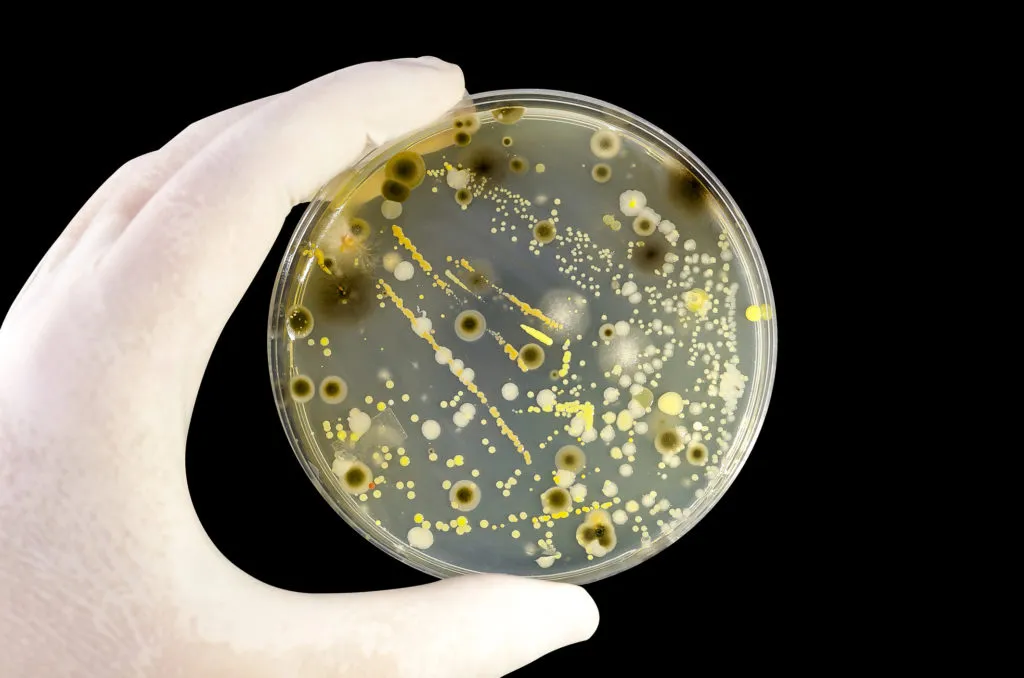
Aquí te decimos como prevenirte de estas bacterias

Las bacterias de han vuelto resistentes a múltiples antibióticos y está alertando a la salud pública mundial.
Por los que investigadores de la Northern Arizona University han advertido que es posible un aumento catastrófico en las muertes relacionadas con infecciones.
Un reciente estudio publicado este diciembre en Communications Medicinerevela habla sobre el uso de antibióticos aumenta globalmente, también lo hace la capacidad de las bacterias para resistirlos.
Es conocido como resistencia multidroga y representa un riesgo significativo. Otra noticia que ha alertado a los investigadores es la aparición de patógenos con resistencia a todos los antibióticos conocidos, denominada panresistencia.

Según Benjamin Koch, autor principal de estudio y científico del Centro de Ciencias de Ecosistemas y Sociedad (Ecoss), esta evolución podría desencadenar un impacto sanitario de magnitudes nunca vistas.
Junto a Koch, el director de Ecoss, Bruce Hungate, y otros expertos de instituciones como la Universidad de Minnesota y la Escuela de Salud Pública del Instituto Milken, llevaron a cabo un modelo predictivo para evaluar las implicaciones de esta amenaza.
Después de los resultados de la investigación se descubrió que una cepa hipotética de E. coli panresistente podría multiplicar las muertes por sepsis entre 18 y 46 veces en tan solo cinco años tras su aparición.
Los investigadores destacan que la velocidad con la que las bacterias están evolucionando hace que sea solo cuestión de tiempo. Esto podría ocurrir dentro de un año o en varias décadas, pero la falta de precisión en las predicciones no disminuye la urgencia del problema.
¿Cómo podemos prevenir estas peligrosas bacterias?
Afortunadamente existen medidas que pueden mitigar sus efectos.
Los efectos de estas bacterias puedes reducirse con políticas que regulen el uso responsable de antibióticos en la producción de alimentos y en la medicina son esenciales, así como la promoción de tecnologías para rastrear la aparición y propagación de la resistencia.
Recomendaciones:
Usar antibióticos únicamente bajo prescripción médica, apoyar políticas que fomenten el desarrollo de nuevos antibióticos y exigir un manejo más responsable de los existentes.
En cuanto a las autoridades deberán regular la legislación sobre el uso de antibióticos y ofrecer incentivos para la investigación de nuevas alternativas terapéuticas.





